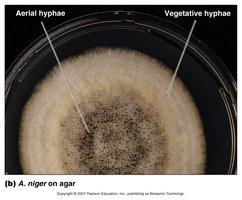
Aerial and vegetative hyphae of Aspergillus niger on agar

BackThe Eukaryotes: Fungi, Protozoans, and Multicellular Parasites
Study Guide - Smart Notes
Tailored notes based on your materials, expanded with key definitions, examples, and context.
Fungi
Introduction to Fungi
Fungi are a diverse group of eukaryotic organisms that play essential roles in ecosystems, industry, and medicine. The study of fungi is known as mycology. Fungi differ significantly from bacteria in their cellular structure, modes of reproduction, and metabolism.

Comparison of Fungi and Bacteria
Fungi and bacteria are both important microorganisms, but they have distinct characteristics. The following table summarizes their main differences:
Feature | Fungi | Bacteria |
|---|---|---|
Cell Type | Eukaryotic | Prokaryotic |
Cell Membrane | Sterols present | Sterols absent (except in Mycoplasma) |
Cell Wall | Glucans, mannans, chitin (no peptidoglycan) | Peptidoglycan |
Spores | Sexual and asexual reproductive spores | Endospores (not for reproduction); some asexual reproductive spores |
Metabolism | Limited to heterotrophic, aerobic, facultatively anaerobic | Heterotrophic, autotrophic, aerobic, facultatively anaerobic, anaerobic |

Fungal Structure
Fungi exist as multicellular (molds) or unicellular (yeasts) forms. The main structural components include:
Hyphae: Long, branching filaments that make up the body (thallus) of a fungus. Hyphae can be septate (with cross-walls) or coenocytic (without cross-walls).
Mycelium: A mass of hyphae forming the vegetative part of a fungus.
Vegetative hyphae: Involved in nutrient absorption.
Aerial hyphae: Involved in reproduction and spore dispersal.
Vegetative Growth and Dimorphism
Fungi can grow as molds or yeasts:
Molds: Consist of hyphae; a mass of hyphae is called a mycelium.
Yeasts: Unicellular fungi that reproduce by budding (asymmetrical division) or fission (symmetrical division).
Dimorphism: Some pathogenic fungi can exist as yeasts at 37°C and as molds at 25°C, a property known as dimorphism.

Fungal Hyphae and Reproduction
Fungi reproduce by forming spores, which can be asexual or sexual. The structure of hyphae and the type of spores produced are important for fungal classification.
Asexual spores: Produced by mitosis; include conidiospores (not enclosed in a sac) and sporangiospores (enclosed in a sac).
Sexual spores: Result from the fusion of nuclei from two mating types and include zygospores, ascospores, and basidiospores.

Yeasts
Yeasts are oval, unicellular fungi that reproduce primarily by budding. Some medically important yeasts include Candida albicans and Saccharomyces cerevisiae.

Fungal Reproductive Structures
Fungi produce a variety of reproductive structures. The following images show examples of conidiospores and sporangiospores:

Medically Important Phyla of Fungi
Fungi are classified into several phyla based on their reproductive structures:
Zygomycota: Conjugation fungi, coenocytic hyphae, produce sporangiospores and zygospores. Example: Rhizopus (black bread mold).
Ascomycota: Sac fungi, septate hyphae, produce ascospores in sacs and conidiospores. Examples: Aspergillus, Blastomyces, Histoplasma.
Basidiomycota: Club fungi, septate hyphae, produce basidiospores. Examples: mushrooms, Cryptococcus.
Anamorphs: Fungi that produce asexual spores only. Examples: Penicillium, Candida.
Microsporidia: Intracellular parasites, lack mitochondria and hyphae. Example: Encephalitozoon intestinalis.

Fungal Diseases (Mycoses)
Fungal infections are called mycoses and are classified by the site of infection:
Systemic mycoses: Deep infections, often begin in the lungs.
Subcutaneous mycoses: Beneath the skin.
Cutaneous mycoses: Affect skin, hair, and nails; caused by dermatophytes.
Superficial mycoses: Affect hair shafts and surface epidermal cells.
Opportunistic mycoses: Caused by normal microbiota or environmental fungi in immunocompromised hosts.

Algae
Introduction to Algae
Algae are simple, photosynthetic eukaryotes found in aquatic environments. They are important producers in food chains and have various industrial uses.

Major Groups of Algae
Dinoflagellates: Unicellular, cellulose in plasma membrane, some produce neurotoxins causing paralytic shellfish poisoning.
Phaeophyta (Brown algae): Multicellular, contain alginic acid, harvested for algin.
Rhodophyta (Red algae): Multicellular, source of agar and carrageenan.
Chlorophyta (Green algae): Unicellular or multicellular, believed to have given rise to plants.
Diatoms: Unicellular, pectin and silica cell walls, produce domoic acid.
Lichens
Lichens are mutualistic associations between a fungus and a green alga or cyanobacterium. They are classified into three groups based on their morphology: crustose, foliose, and fruticose.

Protozoa
Characteristics of Protozoa
Protozoa are unicellular eukaryotes that inhabit water and soil. They exhibit various forms of locomotion and reproduction:
Trophozoite: The active, feeding stage.
Cyst: Dormant, resistant stage for survival in harsh conditions.
Reproduction: Asexual (fission, budding, schizogony) and sexual (conjugation).
Medically Important Protozoa
Diplomonads: Lack mitochondria, multiple flagella. Example: Giardia lamblia.
Parabasalids: Lack mitochondria, multiple flagella, no cyst stage. Example: Trichomonas vaginalis.
Euglenozoa: Move by flagella. Example: Trypanosoma (causes sleeping sickness).
Amebae: Move by pseudopods. Example: Entamoeba histolytica (causes amoebic dysentery).
Apicomplexa: Nonmotile, obligate intracellular parasites. Examples: Plasmodium (malaria), Toxoplasma gondii, Cryptosporidium.
Ciliates: Move by cilia. Example: Balantidium coli.

Helminths
Introduction to Helminths
Helminths are multicellular parasitic worms that infect humans and animals. They are classified into two main phyla:
Platyhelminthes (flatworms): Includes trematodes (flukes) and cestodes (tapeworms).
Nematoda (roundworms): Includes pinworms, hookworms, and others.
General Characteristics
Reduced digestive, nervous, and locomotor systems.
Complex reproductive systems, often producing large numbers of eggs.
Life cycles may involve multiple hosts and larval stages.
Platyhelminthes
Flatworms have an incomplete digestive tract and include:
Trematodes (flukes): Leaf-shaped, have oral and ventral suckers. Example: Clonorchis sinensis, Paragonimus westermani, Schistosoma.
Cestodes (tapeworms): Intestinal parasites with a scolex (head) and proglottids (segments). Example: Taenia saginata.
Nematoda
Roundworms have a complete digestive system. Examples include:
Enterobius vermicularis: Pinworm, common in children.
Ascaris lumbricoides: Most common helminth infection worldwide.
Necator americanus: Hookworm, infects through skin contact with contaminated soil.
Trichinella spiralis: Causes trichinellosis, transmitted by undercooked pork.
Arthropods as Vectors
Role of Arthropods
Arthropods such as insects and arachnids can transmit diseases as vectors. They may transmit pathogens mechanically or biologically (where the pathogen multiplies or undergoes part of its life cycle in the vector).
Class Insecta: Lice, fleas, mosquitoes (6 legs).
Class Arachnida: Mites and ticks (8 legs).
Examples of vector-borne diseases include malaria (mosquito), Lyme disease (tick), and plague (flea).